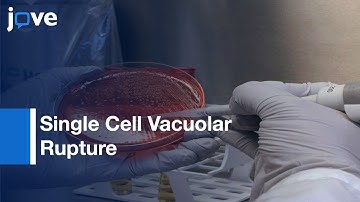
Single Cell Vacuolar Rupture caused by Intracellular Pathogens | Protocol Preview

⬇ DOWNLOAD NOW
Kalau muncul iklan pop-up, tutup lalu klik tombol kembali
Download lagu Optical Trap: Study Of Host-Pathogen Interactions For Dynamic Live Cell Imaging l Protocol Preview secara gratis hanya untuk keperluan promosi. Dukung artis favorit kamu dengan membeli musik original di iTunes atau platform resmi lainnya.
Single Cell Vacuolar Rupture caused by Intracellular Pathogens | Protocol Preview
Single Cell Vacuolar Rupture caused by Intracellular Pathogens | Protocol Preview
 Live-Cell Imaging Fungal Cells:-Entry & Subcellular Localization l Protocol Preview
Live-Cell Imaging Fungal Cells:-Entry & Subcellular Localization l Protocol Preview
 Sequencing Bacterial Microflora In Peripheral Blood: HIV-Infected Patients l Protocol Preview
Sequencing Bacterial Microflora In Peripheral Blood: HIV-Infected Patients l Protocol Preview
 The Rat Race of IMMIGRANTS! Canada is a TRAP! (Do This Instead...)
The Rat Race of IMMIGRANTS! Canada is a TRAP! (Do This Instead...)